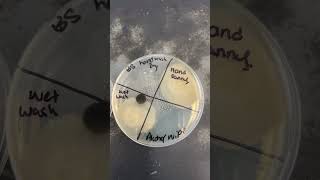

Shared 1 year ago
753K views
Shared 4 months ago
9K views
Shared 2 years ago
94K views
Shared 1 year ago
638K views
Shared 2 years ago
207K views
Shared 7 months ago
2.3K views
Shared 1 year ago
57K views
Shared 4 years ago
22K views
Shared 9 months ago
8.5K views
Shared 1 month ago
1.2K views
Shared 1 year ago
3K views
Shared 1 year ago
16K views
Shared 1 year ago
3.7K views
Shared 3 years ago
79K views
Shared 5 months ago
6.6K views
Shared 1 year ago
326 views
Shared 6 months ago
1.4K views
Shared 2 years ago
23K views
Shared 2 years ago
29K views
Shared 1 year ago
123K views
Shared 3 months ago
7.9K views
Shared 6 months ago
1.1K views
Shared 5 years ago
95K views
Shared 1 year ago
14K views
Shared 1 year ago
1.7K views
Shared 3 years ago
276K views
Shared 1 year ago
1.1K views
Shared 1 year ago
5K views
Shared 1 year ago
19K views